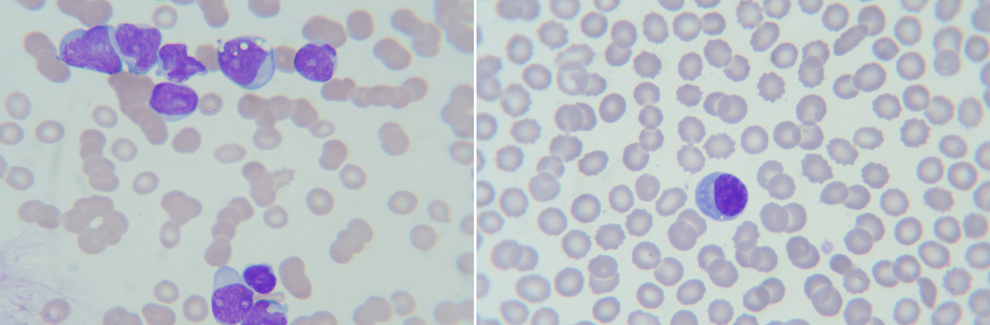
Concurrent Enrollment EDGE Scholarship

Acute Lymphocytic Leukemia
Leukemia is a cancer of white blood cells. In an acute leukemia, the abnormal cells divide rapidly, quickly overtaking functional white and red blood cells. The most common form of cancer in children 0-14 years of age is acute lymphocytic leukemia (ALL). The survival rate in children has improved more than 50% in the last half century. Currently there is a 65.3% overall survival rate; in children under 5 the survival rate increases to 90.4%. Come experience the cancer journey with 6-year-old Noah.